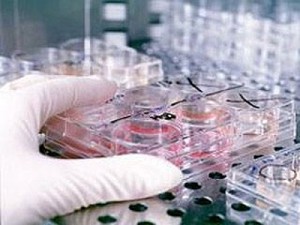

-Поиск по дневнику
-Подписка по e-mail
-Интересы
а также освещение и способствование построению нов воспитание у читателя сознания единства человека и основанного на взаимном уважении и терпимости. цель издания: возрождение духовной и нравственной
-Постоянные читатели
-Статистика
Газета "Шестая раса" – российское издание о личностном и духовном развитии человека, гармоничном взаимодействии человека с окружающим миром, здоровом образе жизни, альтернативных технологиях, о тенденциях нового времени.
Наука об именах |
Загадочную, необъяснимую власть имен над судьбой человека заметили еще древние. В России, например, вплоть до семнадцатого века родители держали в секрете имя, данное ребенку при крещении, пытаясь обмануть тем самым злых духов. В Азербайджане и Турции ребенку давали два имени одно из них было ложным, второе настоящим, все в той же, что и у россиян, надежде ввести в заблуждение недобрых духов. Обычай скрывать свое имя историки и этнографы находят почти у всех народов мира.
Древние были уверены, пишет кандидат исторических наук Александр Горбовский, что судьба человека, города и даже государства предначертана его именем. С этим представлением, по его мнению, связан и сегодняшний обычай перемены имени. Как и у древних, он предполагает и перемену в судьбе. Именно в этом смысл того, что, вступая в брак, женщина берет новое имя (фамилию) мужа. Так поступают писатели и актеры, сочиняя себе псевдоним; меняя имя, принимая пострижение или церковный сан, вступая в тайное общество.
О поражающей однородности характеров и свойств носителей одного и того же имени писал в начале нашего века русский исследователь С. Р. Минцлов. Основываясь на анализе имен выдающихся личностей прошлого, он пришел к выводу, что среди Алексеев чаще всего встречаются расчетливые люди, Александры, как правило, весельчаки, а Петры в большинстве люди тихие, негромкие, но с твердым и упрямым характером. Сергеи, считает Минцлов, очень часто являются отцами выдающихся людей: Пушкин, Грибоедов, Тургенев, Даргомыжский были Сергеевичами. С последним трудно не согласиться, если вспомнить, что из небольшого числа руководителей Советского государства, сыгравших наиболее заметную роль в его истории, двое Хрущев и Горбачев тоже были Сергеевичами.
Павел Флоренский, выдающийся русский ученый и философ, полагал, что имя Александр соответствует в своей основе сангвиническому, с уклоном к холерическому характеру. Александры в отношении к женщинам предупредительны и любезны, но чувство к женщине у них редко взрывает плугом внутреннюю жизнь и чаще ограничивается легким флиртом. С Алексеями хорошо сейчас и нужно быть довольным этим, не рассчитывая особенно на то, что так же хорошо будет и в будущем. Имя Елена знаменует женскую природу, Николай по складу характера очень добр, Василии обычно прячут нежные чувства в себе, Константин отличается непостоянством.
Касаясь мистики имен, В. А. Никонов, специалист в области антропонимики науки об именах, вспоминает в своей книге Имя и общество рассказ Джека Лондона, в котором одна женщина называет своих сыновей именем погибшего любимого брата Самуила, и их всех четверых, одного за другим, уносит смерть. Интересны наблюдения Г. Эйса, который проанализировал триста современных детективных романов и нашел связь между именами и судьбами героев.
По данным газеты За рубежом ( 39, 1986 год), психиатры из США провели исследование и нашли, что люди с забавными и странными именами в четыре раза больше остальных предрасположены к разного рода психическим комплексам, а ребенок с именем, вызывающим насмешки, с самого детства находится в оборонительной позиции, он вынужден бороться за нормальное отношение к себе, что формирует определенные черты его характера. Специалисты из университетов Сан-Диего и Джорджии установили, что учителя в школах упорно ставят низкие оценки учащимся с одними именами, высокие с другими. Девушки с привлекательными именами плохо продвигаются по службе в деловом мире, но зато могут достичь заметных успехов в шоу-бизнесе. Английский терапевт Тревор Уэстон определил, что лица, чьи имена начинаются с букв последней трети алфавита, в три раза чаще подвержены сердечно-сосудистым заболеваниям.
Петр Згонников, кандидат медицинских наук.
www.sunhome.ru
Перейти на сайт газеты "Шестая раса"
Перейти на сайт газеты "Шестая раса"
|
|
Смена имени с точки зрения эниологии |
Не секрет, что многие люди стремятся найти информацию, дающую возможность прочесть судьбу, узнать свое будущее и, по возможности, изменить его. Часто это касается смены имени. Причина данного интереса вполне понятна. Не все хотят жить по сценарию, данному вибрацией полученного при рождении имени. Но только ли имя отражает этот сценарий?
Давайте разберемся и сделаем некую экскурсию по теориям определения значения имени.
В соответствии с, так называемой, псхоэмоциональной теорией имя человека рассматривается как источник психического и эмоционального раздражения, создающий некое поле, которое воздействует на носителя этого имени. Одни имена воспринимаются как мягкие, ласковые, вызывающие приятное чувство, другие твердые, грубые, заставляющие людей ощутить какое-то напряжение. По данной теории воздействие имени (и каждого звука!) можно вычислить и по результатам вычислений составить своего рода «портрет» имени.
Едем дальше. Согласно еще одной теории нумерологической, имя человека это результат действия необратимых вселенских сил, и еще до рождения они так влияют на подсознание родителей, что те дают младенцу именно это имя, а не какое-то другое, выбирая тем самым ему судьбу. Нумерологический анализ имени сложен. Анализ всех цифр имени задача не из легких. Сначала рассматриваются данные даты рождения, имени, отчества, фамилии, и только потом все возможные комбинации в совокупности.
Далее. Есть еще ономатология. Так называется малоизвестная область в науке о языке, которая занимается изучением имени человека. Ведь имен сотни и тысячи старинных и образованных совсем недавно, исконно славянских и заимствованных из неславянских языков, и большинство из них берет свое начало из глубины веков, обладает своей энергетической силой.
В свете вышеизложенного предлагаю читателю поинтересоваться и разобраться-таки, что несет ему его же имя, прежде чем окончательно его сменить. Тем более, что зачастую простая смена (замена) имени просто ничего не даст, кроме кратковременной эйфории. Почему?
А вот сейчас рассмотрим этот вопрос с точки зрения эниологии.
Физическое тело в виде чего-то неизменного воспринимается только нашим четырехмерным сознанием. Например: если атомы в металле были бы размером с теннисный мяч, то расстояние между ними достигало бы 1-го километра. Во всей этой непонятной пустоте существуют электронные связи. В связи с этим, наши физические тела это больше пустота, чем материя. Для того, чтобы создать физическое тело, необходима астрально-ментальная матрица. Если у существующего физического тела заменить матрицу, то и физическое тело перестроится под эту новую матрицу. Сейчас можно подумать, что все, побежали менять имя, а тело уж как-нибудь подстроится. Однако не спешите.
Начнем с того, что имя человека в первую очередь это адрес в Информационном Поле (ИП), причем адрес с подробнейшим описанием ментальной матрицы человека идущего в рождение. И на формирование этой матрицы имеют влияние и родители, и бабушки-дедушки, и церковь с крестными, и т.д.
Приведу примеры. На прием пришла девушка, у которой не складывалась семейная жизнь. Не потому, что она некрасива или плохо воспитана, просто мужчины к ней относятся как к «своему парню». Во время эниокоррекции выяснилось, что родители хотели и ждали в рождение мальчика, а родилась девочка. То есть родители активно формировали матрицу мальчика, а в рождение вышла девочка с матрицей мальчика. Какое уж тут замужество? Кстати и у мальчиков с матрицей девочки судьба не сложится. И это происходит сплошь и рядом, не смотря на существование УЗИ (которое, в отсутствии патологий у родителей, не рекомендуется). А не лучше ли ждать просто ребенка?!
Крайний случай это астральные перехлесты. Это когда независимо от желаний родителей и всех родственников в очередное воплощение выходит мужская сущность женским планом, а женская мужским. В таких случаях у человека речь идет уже не о смене имени, а о смене пола.
Следующий пример. Часто приходят пациенты, которых назвали в честь любимого родственника, знакомого и т.д. Или был проведен обряд крещения и получено имя в честь какого-то святого по всем правилам христианского обряда: с крестными родителями, с обрезанием волос и т.д. Часто бывает и то и другое. Что мы имеем в этом случае? А в этом случае происходит перехлест астрально-ментальной матрицы пациента и того человека, в честь которого пациента назвали. После такого «подарка» и такой «чести» человек живет уже не свою или частично не свою жизнь вследствие кармического перехлеста. Чтобы осознать последствия называния в честь кого-то, узнайте, как жил и как ушел из жизни чествуемый. Интересная картина получается.
При таких условиях смена имени без серьезной проработки в эниокоррекции лишь добавляет еще один адрес в Информационных полях, внося дополнительные напряжения в астрально-ментальную матрицу, а следовательно и в жизнь человека, не решая его проблем. Это конечно же не значит, что имя менять нельзя. Можно. Просто надо для начала разрешить уже существующие проблемы и выявить их причинно-следственные связи, чтобы далее строить свою жизнь по своему разумению.
Координатор НИЦ «ЭНИО»
Альбина Михеева.
Перейти на сайт газеты "Шестая раса"
Перейти на сайт газеты "Шестая раса"
|
|
ООН: презентация прогноза развития цивилизации |
 Совсем недавно в ООН состоялась презентация глобального прогноза развития цивилизации на период до 2050 года. Его разработкой занимались 50 ученых из 10 стран. Новый прогноз показывает, что уровни развития всех стран мира не будут постепенно сближаться, как это представлялось ранее. К сожалению, тенденция пошла в противоположном направлении.
Пока человеческая природа не изменилась на противоположную, альтруистическую, к гармонии с природой, мы будем во всем наблюдать только ухудшение Ученые зря старались Иначе говоря, миру сейчас недостает в большей мере познать эту эгоистическую природу, и вместе с тем выявить, что является ключом, в чем решение этой проблемы, и что может стать лекарством для нее.
Совсем недавно в ООН состоялась презентация глобального прогноза развития цивилизации на период до 2050 года. Его разработкой занимались 50 ученых из 10 стран. Новый прогноз показывает, что уровни развития всех стран мира не будут постепенно сближаться, как это представлялось ранее. К сожалению, тенденция пошла в противоположном направлении.
Пока человеческая природа не изменилась на противоположную, альтруистическую, к гармонии с природой, мы будем во всем наблюдать только ухудшение Ученые зря старались Иначе говоря, миру сейчас недостает в большей мере познать эту эгоистическую природу, и вместе с тем выявить, что является ключом, в чем решение этой проблемы, и что может стать лекарством для нее.Перейти на сайт газеты "Шестая раса"
|
|
Зеленый стиль жизни |
 В нынешнее время наши потребительские аппетиты растут с безумной скоростью, и лишь очень небольшое количество людей представляет, какое влияние на природу имеет наш современный, прежде всего, материальный стиль жизни. Благодаря средствам массовой информации и образовательным заведениям, зародилось направление мировосприятия и стиля жизни, главная идея которого, дружба с окружающей средой, отказ от избыточного потребления, то есть нужно стать ecofriendly. Такой тренд набирает оборотов, и уже стал атрибутом бытия многих людей в странах Западной Европы.
Все, что мы производим или покупаем, имеет свою цену в эквиваленте выбросов углерода в атмосферу ( «углеродный след»). По оценкам ученых, чтобы вернуть эффект глобального потепления на нулевой уровень, нужно уменьшить выбросы до 2,5 т на человека. Возможно ли это сделать? По крайней мере, можно достичь существенного снижения Со2 в атмосфере, если мы будем пытаться изменить наши привычки и стиль жизни.
Быть ecofriendly это не только модно, но и выгодно. Люди экономят на освещении и отоплении помещений, и благодаря переработке уменьшаются расходы экономики стран на добычу сырья. Зеленый стиль жизни открывает также большое пространство для развития экобизнеса новые энергосберегающие технологии, экотуризм, производство тары из материалов, которые достаточно быстро разлагаются.
Показать себя «другом среды» неотъемлемая часть маркетинга для мировых брендов и компаний. Так, если у нас реклама стирального порошка в первую очередь образ хорошей домохозяйки, то на Западе «Ариель» рекламируют, отмечая то, что он очень хорошо выполняет свои функции при 30 градусах. Уменьшив энергетическую стоимость стирки, вы поможете планете.
Фирмы, которые себя уважают, закупают тетради, блокнотики и книги, только при условии, что они изготовлены из продуктов вторичной переработки. То же с мебелью. Древесина переделывается вторично или, по крайней мере, производится из возобновленных лесов. Даже дома возводят только из таких материалов.
Но главная черта «экодруга» это уменьшение своих потребительских аппетитов. Изменив стиль жизни на простой, вы не приобретаете ненужные вещи и уменьшаете количество своего бытового мусора. Плюс отказ от вещей одноразового использования.
Другая черта настоящего друга окружающей среды купленные вещи должны служить в быту долго! Во всей Западной Европе существует давняя и общепринятая практика относительно утилизации и вторичной переработки мусора. Во многих западных семьях отходы сортируют не только на бумагу, стекло или биомусор. Забот значительно больше на бумагу, картон, зеленое, коричневое и белое стекло, пластиковые бутылки, пенопласт, пластик, пивные банки и даже батарейки. Относительно биоотходов, то их с легкостью можно использовать для компоста и таким образом уменьшить нагрузку на мусорохранилища и переработку, помогая огороду или саду. Старые вещи вашего быта, от которых желаете избавиться, тоже нужно сортировать: на древесину, строительные материалы, химикаты, мебель, компьютеры, мобильные телефоны. Все это может пройти вторичную переработку и приносить пользу снова. Экономия средств при этом очевидна, нагрузка на природу существенно уменьшается.
Еще один путь homo ecologicus отношение к тому, что покупаете и как. Эколюди стараются покупать продукты только местного производителя. Во-первых, минимальные энергетические затраты на транспортировку, во-вторых, на обработку и хранение, в-третьих, вы поддерживаете бизнес своего соседа. В конечном итоге, «своя клубника всегда вкуснее». Вместо того чтобы покупать овощи или фрукты из Чили и Новой Зеландии в супермаркете, сходите на какой-нибудь местный рынок.
Экодруг не пойдет в супермаркет с пластиковым пакетом, а будет использовать сумку или корзину, которая может служить значительно дольше. Он, конечно же, отдаст предпочтение велосипеду вместо ежедневной поездки на авто. Кроме уменьшения вредных выбросов и пользы для здоровья, не нужно платить за парковку и бензин. А передвигаться по современному городу на двух колесах быстрее, чем на четырех. Не хотите крутить педаль? Пользуйтесь вместо авто общественным транспортом все равно уменьшите Со2-нагрузку на атмосферу планеты. А, если автомобиль это ежедневная необходимость, эколюди быстрее сядут за руль маленькой экономической малолитражки. К тому же содержание такого авто будет стоить намного дешевле!
www.ecolife.ru
В нынешнее время наши потребительские аппетиты растут с безумной скоростью, и лишь очень небольшое количество людей представляет, какое влияние на природу имеет наш современный, прежде всего, материальный стиль жизни. Благодаря средствам массовой информации и образовательным заведениям, зародилось направление мировосприятия и стиля жизни, главная идея которого, дружба с окружающей средой, отказ от избыточного потребления, то есть нужно стать ecofriendly. Такой тренд набирает оборотов, и уже стал атрибутом бытия многих людей в странах Западной Европы.
Все, что мы производим или покупаем, имеет свою цену в эквиваленте выбросов углерода в атмосферу ( «углеродный след»). По оценкам ученых, чтобы вернуть эффект глобального потепления на нулевой уровень, нужно уменьшить выбросы до 2,5 т на человека. Возможно ли это сделать? По крайней мере, можно достичь существенного снижения Со2 в атмосфере, если мы будем пытаться изменить наши привычки и стиль жизни.
Быть ecofriendly это не только модно, но и выгодно. Люди экономят на освещении и отоплении помещений, и благодаря переработке уменьшаются расходы экономики стран на добычу сырья. Зеленый стиль жизни открывает также большое пространство для развития экобизнеса новые энергосберегающие технологии, экотуризм, производство тары из материалов, которые достаточно быстро разлагаются.
Показать себя «другом среды» неотъемлемая часть маркетинга для мировых брендов и компаний. Так, если у нас реклама стирального порошка в первую очередь образ хорошей домохозяйки, то на Западе «Ариель» рекламируют, отмечая то, что он очень хорошо выполняет свои функции при 30 градусах. Уменьшив энергетическую стоимость стирки, вы поможете планете.
Фирмы, которые себя уважают, закупают тетради, блокнотики и книги, только при условии, что они изготовлены из продуктов вторичной переработки. То же с мебелью. Древесина переделывается вторично или, по крайней мере, производится из возобновленных лесов. Даже дома возводят только из таких материалов.
Но главная черта «экодруга» это уменьшение своих потребительских аппетитов. Изменив стиль жизни на простой, вы не приобретаете ненужные вещи и уменьшаете количество своего бытового мусора. Плюс отказ от вещей одноразового использования.
Другая черта настоящего друга окружающей среды купленные вещи должны служить в быту долго! Во всей Западной Европе существует давняя и общепринятая практика относительно утилизации и вторичной переработки мусора. Во многих западных семьях отходы сортируют не только на бумагу, стекло или биомусор. Забот значительно больше на бумагу, картон, зеленое, коричневое и белое стекло, пластиковые бутылки, пенопласт, пластик, пивные банки и даже батарейки. Относительно биоотходов, то их с легкостью можно использовать для компоста и таким образом уменьшить нагрузку на мусорохранилища и переработку, помогая огороду или саду. Старые вещи вашего быта, от которых желаете избавиться, тоже нужно сортировать: на древесину, строительные материалы, химикаты, мебель, компьютеры, мобильные телефоны. Все это может пройти вторичную переработку и приносить пользу снова. Экономия средств при этом очевидна, нагрузка на природу существенно уменьшается.
Еще один путь homo ecologicus отношение к тому, что покупаете и как. Эколюди стараются покупать продукты только местного производителя. Во-первых, минимальные энергетические затраты на транспортировку, во-вторых, на обработку и хранение, в-третьих, вы поддерживаете бизнес своего соседа. В конечном итоге, «своя клубника всегда вкуснее». Вместо того чтобы покупать овощи или фрукты из Чили и Новой Зеландии в супермаркете, сходите на какой-нибудь местный рынок.
Экодруг не пойдет в супермаркет с пластиковым пакетом, а будет использовать сумку или корзину, которая может служить значительно дольше. Он, конечно же, отдаст предпочтение велосипеду вместо ежедневной поездки на авто. Кроме уменьшения вредных выбросов и пользы для здоровья, не нужно платить за парковку и бензин. А передвигаться по современному городу на двух колесах быстрее, чем на четырех. Не хотите крутить педаль? Пользуйтесь вместо авто общественным транспортом все равно уменьшите Со2-нагрузку на атмосферу планеты. А, если автомобиль это ежедневная необходимость, эколюди быстрее сядут за руль маленькой экономической малолитражки. К тому же содержание такого авто будет стоить намного дешевле!
www.ecolife.ruПерейти на сайт газеты "Шестая раса"
|
|
Кризис медицины в 21-м веке |
 Треть всех денег, выделяемых администрацией Обамы на стимуляцию экономики, планируется использовать для преодоления кризиса в медицине США. Но давайте посмотрим, каковы предпосылки этого кризиса?
Чтобы сэкономить, пациенты стали реже посещать врачей, поскольку каждый визит помимо страховки требует дополнительных денег. В результате искусственно выросла цена страховок.
Выросло также количество дорогостоящих анализов, лекарств и процедур по каждому отдельному заболеванию. Поэтому вслед за стремительным ростом безработицы ожидается огромная гвардия пациентов, нуждающихся в государственной медицинской страховке.
Больницы, так же как и банки, и автомобильная промышленность, находятся в плачевном состоянии. А правительство пытается спасти положение, пользуясь теми же методами, которые привели медицину в кризис.
Это напоминает ситуацию, когда человека, работающего огромным молотом и разрушающего стены, попросили не меняя инструмента починить деликатные швейцарские часы. Нетрудно предугадать, каков будет результат.
Так в чем же заключается главная причина кризиса? Она - в нашем эго, которое день ото дня только растет. И каждый из участников медицинского бизнеса, как со стороны врачей, так и со стороны пациентов, пытается усладить это ненасытное эго.
Деньги встали во главу угла и затмили саму причину возникновения медицины. Исчезли правильные взаимоотношения между пациентом и врачом. Прежде пациент приходил к врачу за помощью и советом.
Врач относился к пациенту как к члену семьи. Нередко врач присутствовал на свадьбах, днях рождениях и прочих семейных торжествах. Было уважение. Куда оно делось? Его заменили другие ценности.
Нынче врач оценивается не по человеческим и профессиональным качествам и желанию выполнить свой врачебный долг, а по количеству денег и наличию ценностей, которые понятны современному человеку: Мерседес, яхта, огромный дом, экзотические эксклюзивные путешествия и т.д.
Как же так получилось, что, несмотря на то, что технологии улучшились, и наука изобрела много нового в диагностике и лечении, среднестатистическая смертность и заболеваемость не изменились?
Медицина действительно стала лучше. Но основная проблема в том, что ее применение основано на принципах наживы. Современный подход к пониманию эффективности медицины - какую прибыль можно получить на вложенный доллар. И так во всем, чего не коснешься, - и в отношении лекарств, и анализов, и пребывания в больнице.
Исчезло главное - взаимное доверие между врачом и пациентом. Теперь зачастую пациент приходит на прием с огромным недоверием, заранее выяснив в интернете все, что можно о своем состоянии. Подозревая врача в том, что тот хочет на нем бесстыдно заработать.
С другой стороны, 90% решений о том, что делать с пациентом, диктуется защитой от потенциального суда за медицинскую ошибку. Пациент смотрит на доктора, как на машину по выкачиванию денег из пациента. А с другой стороны, прикидывает, как можно заработать на докторе... Вот так и стоят два противника в состоянии готовности нанести удар первым.
Сам принцип медицинских страховок, так же как и принцип займа в банках, основан на выгоде, а не на заботе о том, кому предоставляешь услуги. Все устроено так, чтобы люди платили деньги, но страховкой не пользовались. В результате пациенты перестали вовремя обращаться к врачам и списки записи на прием поредели.
Заглянем в глубь веков и посмотрим, как выглядела первая модель медицинской страховки. Около четырех тысяч лет назад в Китае целитель шел утром по деревне. В каждом доме рядом с входом стояла ваза. Он опускал руку в вазу и вытаскивал оттуда монету. Это означало, что в доме все здоровы.
А если в вазе не было монеты, это означало, что кто-то болен. Врач входил в дом и по возможности исцелял страдающего. При этом травы, иголки и все прочее было включено в отсутствие монеты.
В свободное время целитель занимался Тай Чи с жителями деревни, ходил по домам и следил за тем, чтобы питание и образ жизни были правильными. Тот, кто не подчинялся правилам страховки, скажем, из лени не занимался каждое утро зарядкой, исключался из круга обхода целителя.
Этот принцип противоположен тому, что существует сейчас. Ведь деньги получали за искусство поддерживать здоровье, а не за болезнь. Тут есть о чем задуматься... Может, стоит вновь перейти на принцип древних целителей? Платить не за болезнь и каждое действие по диагностике и лечению, а за здоровье. Тогда из медицины уйдут все те, кто паразитируют на горе человека и его недуге.
Конечно, то, что естественно существовало в маленькой деревне с неразвитым эгоизмом 4 тысячи лет назад, в наше глобальное время развитого эгоизма можно повторить только в случае его исправления.
Какой путь мы выберем? Кувалдой по швейцарским часам или найдем в кармане забытые тонкие инструменты - отдачу, вместо получения? Что вы думаете?
kabmir.com
Треть всех денег, выделяемых администрацией Обамы на стимуляцию экономики, планируется использовать для преодоления кризиса в медицине США. Но давайте посмотрим, каковы предпосылки этого кризиса?
Чтобы сэкономить, пациенты стали реже посещать врачей, поскольку каждый визит помимо страховки требует дополнительных денег. В результате искусственно выросла цена страховок.
Выросло также количество дорогостоящих анализов, лекарств и процедур по каждому отдельному заболеванию. Поэтому вслед за стремительным ростом безработицы ожидается огромная гвардия пациентов, нуждающихся в государственной медицинской страховке.
Больницы, так же как и банки, и автомобильная промышленность, находятся в плачевном состоянии. А правительство пытается спасти положение, пользуясь теми же методами, которые привели медицину в кризис.
Это напоминает ситуацию, когда человека, работающего огромным молотом и разрушающего стены, попросили не меняя инструмента починить деликатные швейцарские часы. Нетрудно предугадать, каков будет результат.
Так в чем же заключается главная причина кризиса? Она - в нашем эго, которое день ото дня только растет. И каждый из участников медицинского бизнеса, как со стороны врачей, так и со стороны пациентов, пытается усладить это ненасытное эго.
Деньги встали во главу угла и затмили саму причину возникновения медицины. Исчезли правильные взаимоотношения между пациентом и врачом. Прежде пациент приходил к врачу за помощью и советом.
Врач относился к пациенту как к члену семьи. Нередко врач присутствовал на свадьбах, днях рождениях и прочих семейных торжествах. Было уважение. Куда оно делось? Его заменили другие ценности.
Нынче врач оценивается не по человеческим и профессиональным качествам и желанию выполнить свой врачебный долг, а по количеству денег и наличию ценностей, которые понятны современному человеку: Мерседес, яхта, огромный дом, экзотические эксклюзивные путешествия и т.д.
Как же так получилось, что, несмотря на то, что технологии улучшились, и наука изобрела много нового в диагностике и лечении, среднестатистическая смертность и заболеваемость не изменились?
Медицина действительно стала лучше. Но основная проблема в том, что ее применение основано на принципах наживы. Современный подход к пониманию эффективности медицины - какую прибыль можно получить на вложенный доллар. И так во всем, чего не коснешься, - и в отношении лекарств, и анализов, и пребывания в больнице.
Исчезло главное - взаимное доверие между врачом и пациентом. Теперь зачастую пациент приходит на прием с огромным недоверием, заранее выяснив в интернете все, что можно о своем состоянии. Подозревая врача в том, что тот хочет на нем бесстыдно заработать.
С другой стороны, 90% решений о том, что делать с пациентом, диктуется защитой от потенциального суда за медицинскую ошибку. Пациент смотрит на доктора, как на машину по выкачиванию денег из пациента. А с другой стороны, прикидывает, как можно заработать на докторе... Вот так и стоят два противника в состоянии готовности нанести удар первым.
Сам принцип медицинских страховок, так же как и принцип займа в банках, основан на выгоде, а не на заботе о том, кому предоставляешь услуги. Все устроено так, чтобы люди платили деньги, но страховкой не пользовались. В результате пациенты перестали вовремя обращаться к врачам и списки записи на прием поредели.
Заглянем в глубь веков и посмотрим, как выглядела первая модель медицинской страховки. Около четырех тысяч лет назад в Китае целитель шел утром по деревне. В каждом доме рядом с входом стояла ваза. Он опускал руку в вазу и вытаскивал оттуда монету. Это означало, что в доме все здоровы.
А если в вазе не было монеты, это означало, что кто-то болен. Врач входил в дом и по возможности исцелял страдающего. При этом травы, иголки и все прочее было включено в отсутствие монеты.
В свободное время целитель занимался Тай Чи с жителями деревни, ходил по домам и следил за тем, чтобы питание и образ жизни были правильными. Тот, кто не подчинялся правилам страховки, скажем, из лени не занимался каждое утро зарядкой, исключался из круга обхода целителя.
Этот принцип противоположен тому, что существует сейчас. Ведь деньги получали за искусство поддерживать здоровье, а не за болезнь. Тут есть о чем задуматься... Может, стоит вновь перейти на принцип древних целителей? Платить не за болезнь и каждое действие по диагностике и лечению, а за здоровье. Тогда из медицины уйдут все те, кто паразитируют на горе человека и его недуге.
Конечно, то, что естественно существовало в маленькой деревне с неразвитым эгоизмом 4 тысячи лет назад, в наше глобальное время развитого эгоизма можно повторить только в случае его исправления.
Какой путь мы выберем? Кувалдой по швейцарским часам или найдем в кармане забытые тонкие инструменты - отдачу, вместо получения? Что вы думаете?
kabmir.comПерейти на сайт газеты "Шестая раса"
|
|
Письмо в редакцию |
Здравствуйте! Сегодняшнее откровение моей души привело к волнующей теме. Эта тема касается не только одной меня и обременяет своей тайной не только мою душу, но, я думаю, что и всё человечество в целом. С покон веков, человечество на Земле стояло перед выбором и результаты его легли в Историческую основу всех времён и народов. Сегодня наше положение ничем не отличается от прошлых времён, - мы снова стоим перед главным выбором и, от того что мы выберем, зависит не только наше будущее, но и будущее всей планеты. Наступили времена Великих перемен и они обязывают нас сделать, наконец, этот выбор. Сегодня нам предстоит здорово потрудиться и преодолеть очень многое в нашей жизни, чтобы спасти себя и нашу планету. Я хочу приоткрыть перед вами завесу, которая поможет каждому задуматься над образом своей жизни, о помыслах своих и деяниях, затронув тему предстоящего «конца света», который в большинстве версий назначен на 2012 год. Кто назначил? В этом вопросе каждый из нас должен разобраться самостоятельно. О «конце света» вещают все СМИ, об этом снимают фильмы, об этом написано в книгах, каждая из которых заявляет об истинности изложенной в ней информации. Что же нам делать со всем этим? Где искать правду и как отличить Истину от лжи? Способны ли мы сегодня сделать это качественно? Думаю, что не способны. Чистоту информации человек способен принять лишь тогда, когда чиста его душа, когда она свободна от жадности, от зависти, от злобы и обид, от желаний материального мира. Таков ли сейчас человек? Нет, не таков. Сегодня мы только учимся быть такими: освобождаться от пороков, искренне радоваться жизни, прощать и просить прощения, учимся Любить и быть по-настоящему счастливыми.
Для многих из нас представление о счастье до сих пор искажено нашим сознанием. Мы видим его в дорогих вещах, машинах, во власти, которую желаем обрести как угодно, достигая «высокого» положения в обществе, в количестве денег, во всём, что можно купить за деньги. Пришло время исправлять ошибки и изменить наше представление о счастье. Пришло время обратиться, наконец, к собственной душе, пересмотреть её содержание, выбросить мусор и оставить только то, чем душа была наделена изначально. Пришло время, наконец, познать свою собственную суть и разобраться со всем тем, что поистине угрожает нашей жизни и планете.
Независимо от того, пугают ли нас планетарной катастрофой или просто предупреждают об опасности, верим ли мы в это или не верим, давайте не будем бояться, а возьмёмся за руки и начнём бороться со злом внутри и вокруг себя вместе! Давайте вместе будем учиться быть послушными детьми Отца! Давайте сплотимся воедино, и начнём вместе радоваться жизни, несмотря ни на что, вместе учиться признавать свои ошибки, каяться, учиться прощать друг друга и просить друг у друга прощения, учиться видеть вокруг себя Божественную красоту, а не ослепляющий блеск иллюзорного мирка. Давайте, проснувшись поутру, прочитаем Молитву за себя и за всех своих близких и родных, подойдём к окну и искренне порадуемся Солнышку, пожелаем Счастья, Мира и Любви всем своим собратьям, всем существам, живущим на нашей замечательной планете. Давайте помолимся за тех, кому трудно преодолеть свои пороки, за тех, кто носит камень в душе. Ведь в единстве друг с другом, с Верой, Надеждой и Любовью мы одерживали уже не одну Победу в битве с алчностью и злом. Давайте жить каждый день с Молитвой, пока она не станет частью нас самих, пока душа не сольётся с нею воедино и не превратится в прекрасную песню. И пусть эта песня звучит без конца в наших сердцах! Давайте вспомним о том, Кто Мы Есмь! Давайте объединим Силу наших мыслей и Силу слова с Силой Молитвы и поверим в то, что Победа будет за нами, что беда обойдёт нас стороной, что Человечество и Земля снова познают Истинное Счастье от Божественной Любви, что вновь расцветут сады на Земле нашей! Давайте сделаем это все вместе! Давайте!
Каждое утро мы с мужем читаем Молитвы и верим, что в этот момент на Земле происходит чудо, потому что оно происходит и в наших душах. Молитва чудесным образом помогает нам преодолевать все трудности. Молитва учит нас искренне Любить друг друга и всех, кто рядом с нами, чего и вам желаем!
«Да раскроются очи духа вашего к Свету и Миру, что в человеке живут!
Да прольётся Любовь ваша к ранам его, и милосердие Господа да залечит их!
Да будет день ваш Красотою, песнью действенной Любви, Мира и Радости!»
Аминь.
А это моё новое стихотворение для вас. До новых встреч!
Что есть Молитва? Это просто чудо!
Истоки Творчества её лежат в веках...
Молитвы суть слагал Великий Будда
И воплощал ту суть в людских сердцах.
Он обладал великой Силой слова,
Творя Молитвы в песенных устах.
К сотворчеству он призывал готовых
Пройти свой Путь, преодолевших страх.
Он воскрешал Молитвой души спящих.
Учил по совести и чести жить,
Чтоб отличать от правды ложь смердящих,
В единстве с Богом чудный мир творить.
Познавший суть Молитв, познает Силу,
Что вложена в неё самим Творцом.
О, Господи, прости нас и помилуй,
Коль до сих пор идём иным путём!
Мы примем дар Божественный и снова
Очистим в воплощениях сердца!
Мы воскресим Молитвой Силу слова,
Чтоб Истина звучала без конца!
С уважением, Елена Григоренко, г. Благовещенск.
Перейти на сайт газеты "Шестая раса"
Перейти на сайт газеты "Шестая раса"
|
|
Воспитание ребенка и чувство вины |
 Воспитание ребенка и чувство вины Вина захлёстывает родителей по любому поводу. Вам может казаться, что из-за вас малыш не спит по ночам, что у него поднялась температура, что ваш любимый ученик схватил очередную двойку, что у дочки не складываются отношения с подружками, что сын связался не с той компанией, что тысячи «что». Может быть, это и так. Но если вы погружаетесь в свою виноватость, становится очень трудно фактически невозможно найти правильное решение, понять ребёнка и помочь ему.
Вина отбирает силы, из-за неё вы погружаетесь с головой куда угодно: в гнев, в депрессию, в сожаление, в раскаяние, самоедство. А возвращаетесь совершенно опустошёнными и обессиленными. Беда в том, что хорошие родители слишком сурово к себе относятся. Со стороны, внешне, это не заметно, но в глубине души папы, а ещё больше мамы грызут себя. Поводов для этого великое множество, и каждый выбирает свой. В зависимости от программы, которая сидит в голове. Вот самый простой пример. Всех нас с детства приучали к порядку. Но если у наших собственных родителей был на этом бзик, то и дети будут слегка на нём помешаны. Придите на любую детскую площадку и вы обязательно встретите маму, которая твердит малышу: «Грязно, не трогай, не упади, испачкаешься» У такой мамы скорее всего и дома идеальный порядок. Она бесконечно что-то очищает и оттирает, тратя на это массу сил. Кому это надо? Ребёнку точно нет. Спросите саму маму, и она, что-то пробормотав про микробы и культуру, даже самой себе не сможет вразумительно объяснить, зачем надо переодевать малыша по сто раз в день и почему ей так нужен парадный ребёнок. Что это? Работает программа. И чувство вины, и попытки перенести свой жизненный опыт на ребёнка, и погоня за идеалом всё это результаты зомбирования, вбитых в наше подсознание старых программ. Мы не хотим сказать, что ребёнок должен быть вечно чумазым, но если вас трясёт от вида грязных ладоней, и вы готовы полночи перестирывать его рубашку, то спросите себя: зачем? Каждый раз, когда мы с сыном возвращались из детского сада, на нашем пути возникало непреодолимое препятствие в виде магазина детских игрушек. Здесь замедлялись шаги, а потом произносилась одна и та же фраза: «Мам, я только посмотрю, ладно?» Я кивала головой, и мой малыш, тихо вздыхая, приступал к созерцанию выставленных в витрине монстров. Не знаю, как ему это удавалось, но, хотя он не умолял, не ныл и не требовал, мы почему-то обязательно заходили в магазин и я обязательно покупала ему очередное пластмассовое безобразие. Покупала, хотя и чувствовала, что опять делаю что-то не то. Во-первых, это абсолютно непедагогично покупать по монстру каждый вечер, а во-вторых, бесполезно, потому что через час-полтора мой мальчик (я точно знала) разберёт эту штуковину на запчасти и забросит куда подальше. Так дело и шло. Он вздыхал, я покупала, я покупала, он ломал. Но однажды, когда во время генеральной уборки все тушки этих самых монстров были выужены мною на свет божий и сложены в кучку, а куча оказалась ой-ой какой внушительной, меня вдруг осенило: а мой ненаглядный сынок талантливый манипулятор. А я, соответственно, полная растяпа, которая идёт у него на поводу. «Всё! сказала я сама себе, никаких киосков, утыканных монстрами». Я была полна решимости, честное слово. И через пару недель с удивлением обнаружила, что ничего, в сущности, не изменилось. Монстров мы, правда, больше не покупали, но но дом заполонили детские комиксы и киндерсюрпризы. В общем, как в математике: от перемены мест слагаемых сумма не меняется. А сумма (в смысле: цена) меня волновала. И не столько денежная, сколько моральная. За что я плачу? А платила я за то же, за что расплачиваются многие поколения сознательных родителей. За спокойную совесть. Покупки это следствие. Причина была в другом. В группе сменилась воспитательница, и сын разом разлюбил детский сад. Каждое утро он просил оставить его дома это раз. А я всё равно вела (а куда, собственно, мне было деваться?) это два. Раскаивалась и «исправлялась» очищала свою совесть вот этой самой очередной безделушкой это три. Устный счёт всё расставил по местам. Теперь я знала, почему делаю то, за что сама же себя и осуждаю. Из-за чувства вины, которое удобно расположилось где-то внутри меня и ныло, ныло, ныло Оставалось принять какие-то меры. Я пошла в детский сад, поговорила с воспитательницей, она мягче и внимательней стала относиться к мальчику, и проблемы закончились. И просто чудо! ушла проблема ушло чувство вины! Игрушки, конечно, покупать мы продолжали, но теперь я могла спокойно сказать ребёнку «нет», когда это было необходимо. Не позволяйте себе быть виноватыми! Что случается с виноватыми родителями Давайте посмотрим, что происходит, когда мы погружаемся в чувство вины: 1. Попадаем в зависимость от своих деток. И тогда: а) усиленно опекаем их, задабриваем, заискиваем, задариваем, становимся снисходительными там, где надо проявить твёрдость и характер, в общем, попустительствуем; б) или, наоборот, становимся слишком строгими, грубыми, нетерпеливыми, авторитарными родителями. 2. Осуждаем себя и попусту теряем энергию, силы и время: силы уходят не на то, чтобы исправить, а на то, чтобы покаяться. И тогда: дети манипулируют нами. 3. Ищем виноватых. И тогда: перекладываем ответственность на чужие плечи. 4. Формируем у собственного ребёнка стойкое чувство вины («если бы ты»). И тогда: падает его самооценка, ребёнок теряет уверенность, он низко себя ценит, а мы, выходит, готовим его к неудачам и повторению собственных ошибок. 5. Теряем ориентиры. И тогда: дети перестают верить в нашу безусловную любовь. Без вины виноватые дети Вина это как плотина на пути любви. Она не даёт любви течь свободно и открыто. Она заставляет нас суетиться, стыдиться, требовать, надрываться, проверять и всё равно ощущать себя неполноценными родителями неполноценных детей. Как-то после родительского собрания ко мне подошёл один папа с жалобами на своего сына-подростка: какой он грубый, непутёвый, ленивый, с матерью ещё говорит нормально, а меня (отца родного) совершенно не желает признавать. Разговор у нас получился долгий, и вот что выяснилось. Когда-то папа мечтал вырастить из сына спортсмена и приложил, по его словам, немало усилий. Регулярно он сдавал ребёнка в спортивные секции. Именно «сдавал», так как сам сын туда не рвался. Футбол, баскетбол, тяжёлая атлетика, лёгкая, бокс попробовали всё, но мальчик не приживался нигде. Как знать, может, он просто уродился неспортивным, а может, не увидел в этом смысла. Сначала папа переживал, сердился, но ничего не мог сделать. Поначалу винил себя за то, что у самого нет времени заняться сыном. Но постепенно акценты как-то сместились. Неспортивный сын стал для отца раздражающим фактором, напоминанием о собственной вине. И такие чувства, как злость (на себя) и недовольство (собою), отец перенёс на ребёнка. Он стал обвинять сына в том, в чём поначалу считал виноватым себя. И постепенно слово «спорт» в этом доме превратилось в синоним слова «бездельник» и «лоботряс», а отношения разладились окончательно. Отца ослепило чувство вины. Он не видел, что ещё может сделать, потому что все его эмоции ушли на обвинение, а не на поиски выхода. Мог бы этот папа приобщить сына к спорту и сохранить хорошие отношения с ним? Думается, что да. Во-первых, он мог бы честно признаться себе: да, я чувствую, что виноват, потому что не занимаюсь сыном. Во-вторых: а) делать то, что возможно (что мальчику по силам). Зимой покататься на лыжах, летом плавать вместе, погонять мяч, пока жарятся шашлыки, полазить по деревьям, побегать по траве, а дома кувыркаться на турнике и на ковре побороться Заменить натаскивание весёлой игрой и просто общаться при этом. Это так здорово! Может быть, мальчик не стал бы спортсменом, но друзьями они бы стали это точно. Или б) в крайнем случае, папа мог оставить ребёнка в покое. Ну не спортсмен он и всё. Не стоит заставлять детей делать то, что вы сами сделать не в состоянии (не хотите). Вы можете предложить, вы можете агитировать, но не навязывать. Это всё-таки лучше, чем самому маяться виною (что не сумели) и постепенно внушать то же чувство ребёнку. Вина раскалывает человека пополам: одна его часть говорит «надо», другая говорит «не могу/не хочу». Уж лучше выбрать что-то одно и не раздваиваться. И жить станет легче, и проблемы воспитательные станет решать куда проще. А главное вы сохраните взаимопонимание со своими детьми. Правда, пока ребёнок маленький, нас не очень-то и волнует вопрос взаимопонимания. Просто потому, что маленькие дети, как локаторы, настроены на приём. Они принимают наши сигналы (читай: команды, советы), не критикуя и не утруждая себя выяснением: «А зачем мне это надо?» Но чем старше они становятся, тем чаще в их милые головки приходит: «А действительно, зачем мне это надо?» Критичность и лёгкий скептицизм неотъемлемая составляющая роста и осознания себя как личности. А подростку уж просто жизненно важно понять суть наших претензий и требований. Он готов критиковать и сомневаться всегда, даже в ущерб себе, даже рискуя потерять наше расположение и уважение. И родителям надо иметь ангельское терпение, чтоб не поддаться на провокацию и найти, найти, найти контакт. Самый важный шаг к этому избавиться от чувства вины. Напишите на листе бумаги: Винить нельзя помиловать. И поставьте в этом предложении запятую там, где она должна стоять: перед последним словом. Отрывок из книги З. и Н. Некрасовых «Перестаньте детей воспитывать - помогите им расти».
Воспитание ребенка и чувство вины Вина захлёстывает родителей по любому поводу. Вам может казаться, что из-за вас малыш не спит по ночам, что у него поднялась температура, что ваш любимый ученик схватил очередную двойку, что у дочки не складываются отношения с подружками, что сын связался не с той компанией, что тысячи «что». Может быть, это и так. Но если вы погружаетесь в свою виноватость, становится очень трудно фактически невозможно найти правильное решение, понять ребёнка и помочь ему.
Вина отбирает силы, из-за неё вы погружаетесь с головой куда угодно: в гнев, в депрессию, в сожаление, в раскаяние, самоедство. А возвращаетесь совершенно опустошёнными и обессиленными. Беда в том, что хорошие родители слишком сурово к себе относятся. Со стороны, внешне, это не заметно, но в глубине души папы, а ещё больше мамы грызут себя. Поводов для этого великое множество, и каждый выбирает свой. В зависимости от программы, которая сидит в голове. Вот самый простой пример. Всех нас с детства приучали к порядку. Но если у наших собственных родителей был на этом бзик, то и дети будут слегка на нём помешаны. Придите на любую детскую площадку и вы обязательно встретите маму, которая твердит малышу: «Грязно, не трогай, не упади, испачкаешься» У такой мамы скорее всего и дома идеальный порядок. Она бесконечно что-то очищает и оттирает, тратя на это массу сил. Кому это надо? Ребёнку точно нет. Спросите саму маму, и она, что-то пробормотав про микробы и культуру, даже самой себе не сможет вразумительно объяснить, зачем надо переодевать малыша по сто раз в день и почему ей так нужен парадный ребёнок. Что это? Работает программа. И чувство вины, и попытки перенести свой жизненный опыт на ребёнка, и погоня за идеалом всё это результаты зомбирования, вбитых в наше подсознание старых программ. Мы не хотим сказать, что ребёнок должен быть вечно чумазым, но если вас трясёт от вида грязных ладоней, и вы готовы полночи перестирывать его рубашку, то спросите себя: зачем? Каждый раз, когда мы с сыном возвращались из детского сада, на нашем пути возникало непреодолимое препятствие в виде магазина детских игрушек. Здесь замедлялись шаги, а потом произносилась одна и та же фраза: «Мам, я только посмотрю, ладно?» Я кивала головой, и мой малыш, тихо вздыхая, приступал к созерцанию выставленных в витрине монстров. Не знаю, как ему это удавалось, но, хотя он не умолял, не ныл и не требовал, мы почему-то обязательно заходили в магазин и я обязательно покупала ему очередное пластмассовое безобразие. Покупала, хотя и чувствовала, что опять делаю что-то не то. Во-первых, это абсолютно непедагогично покупать по монстру каждый вечер, а во-вторых, бесполезно, потому что через час-полтора мой мальчик (я точно знала) разберёт эту штуковину на запчасти и забросит куда подальше. Так дело и шло. Он вздыхал, я покупала, я покупала, он ломал. Но однажды, когда во время генеральной уборки все тушки этих самых монстров были выужены мною на свет божий и сложены в кучку, а куча оказалась ой-ой какой внушительной, меня вдруг осенило: а мой ненаглядный сынок талантливый манипулятор. А я, соответственно, полная растяпа, которая идёт у него на поводу. «Всё! сказала я сама себе, никаких киосков, утыканных монстрами». Я была полна решимости, честное слово. И через пару недель с удивлением обнаружила, что ничего, в сущности, не изменилось. Монстров мы, правда, больше не покупали, но но дом заполонили детские комиксы и киндерсюрпризы. В общем, как в математике: от перемены мест слагаемых сумма не меняется. А сумма (в смысле: цена) меня волновала. И не столько денежная, сколько моральная. За что я плачу? А платила я за то же, за что расплачиваются многие поколения сознательных родителей. За спокойную совесть. Покупки это следствие. Причина была в другом. В группе сменилась воспитательница, и сын разом разлюбил детский сад. Каждое утро он просил оставить его дома это раз. А я всё равно вела (а куда, собственно, мне было деваться?) это два. Раскаивалась и «исправлялась» очищала свою совесть вот этой самой очередной безделушкой это три. Устный счёт всё расставил по местам. Теперь я знала, почему делаю то, за что сама же себя и осуждаю. Из-за чувства вины, которое удобно расположилось где-то внутри меня и ныло, ныло, ныло Оставалось принять какие-то меры. Я пошла в детский сад, поговорила с воспитательницей, она мягче и внимательней стала относиться к мальчику, и проблемы закончились. И просто чудо! ушла проблема ушло чувство вины! Игрушки, конечно, покупать мы продолжали, но теперь я могла спокойно сказать ребёнку «нет», когда это было необходимо. Не позволяйте себе быть виноватыми! Что случается с виноватыми родителями Давайте посмотрим, что происходит, когда мы погружаемся в чувство вины: 1. Попадаем в зависимость от своих деток. И тогда: а) усиленно опекаем их, задабриваем, заискиваем, задариваем, становимся снисходительными там, где надо проявить твёрдость и характер, в общем, попустительствуем; б) или, наоборот, становимся слишком строгими, грубыми, нетерпеливыми, авторитарными родителями. 2. Осуждаем себя и попусту теряем энергию, силы и время: силы уходят не на то, чтобы исправить, а на то, чтобы покаяться. И тогда: дети манипулируют нами. 3. Ищем виноватых. И тогда: перекладываем ответственность на чужие плечи. 4. Формируем у собственного ребёнка стойкое чувство вины («если бы ты»). И тогда: падает его самооценка, ребёнок теряет уверенность, он низко себя ценит, а мы, выходит, готовим его к неудачам и повторению собственных ошибок. 5. Теряем ориентиры. И тогда: дети перестают верить в нашу безусловную любовь. Без вины виноватые дети Вина это как плотина на пути любви. Она не даёт любви течь свободно и открыто. Она заставляет нас суетиться, стыдиться, требовать, надрываться, проверять и всё равно ощущать себя неполноценными родителями неполноценных детей. Как-то после родительского собрания ко мне подошёл один папа с жалобами на своего сына-подростка: какой он грубый, непутёвый, ленивый, с матерью ещё говорит нормально, а меня (отца родного) совершенно не желает признавать. Разговор у нас получился долгий, и вот что выяснилось. Когда-то папа мечтал вырастить из сына спортсмена и приложил, по его словам, немало усилий. Регулярно он сдавал ребёнка в спортивные секции. Именно «сдавал», так как сам сын туда не рвался. Футбол, баскетбол, тяжёлая атлетика, лёгкая, бокс попробовали всё, но мальчик не приживался нигде. Как знать, может, он просто уродился неспортивным, а может, не увидел в этом смысла. Сначала папа переживал, сердился, но ничего не мог сделать. Поначалу винил себя за то, что у самого нет времени заняться сыном. Но постепенно акценты как-то сместились. Неспортивный сын стал для отца раздражающим фактором, напоминанием о собственной вине. И такие чувства, как злость (на себя) и недовольство (собою), отец перенёс на ребёнка. Он стал обвинять сына в том, в чём поначалу считал виноватым себя. И постепенно слово «спорт» в этом доме превратилось в синоним слова «бездельник» и «лоботряс», а отношения разладились окончательно. Отца ослепило чувство вины. Он не видел, что ещё может сделать, потому что все его эмоции ушли на обвинение, а не на поиски выхода. Мог бы этот папа приобщить сына к спорту и сохранить хорошие отношения с ним? Думается, что да. Во-первых, он мог бы честно признаться себе: да, я чувствую, что виноват, потому что не занимаюсь сыном. Во-вторых: а) делать то, что возможно (что мальчику по силам). Зимой покататься на лыжах, летом плавать вместе, погонять мяч, пока жарятся шашлыки, полазить по деревьям, побегать по траве, а дома кувыркаться на турнике и на ковре побороться Заменить натаскивание весёлой игрой и просто общаться при этом. Это так здорово! Может быть, мальчик не стал бы спортсменом, но друзьями они бы стали это точно. Или б) в крайнем случае, папа мог оставить ребёнка в покое. Ну не спортсмен он и всё. Не стоит заставлять детей делать то, что вы сами сделать не в состоянии (не хотите). Вы можете предложить, вы можете агитировать, но не навязывать. Это всё-таки лучше, чем самому маяться виною (что не сумели) и постепенно внушать то же чувство ребёнку. Вина раскалывает человека пополам: одна его часть говорит «надо», другая говорит «не могу/не хочу». Уж лучше выбрать что-то одно и не раздваиваться. И жить станет легче, и проблемы воспитательные станет решать куда проще. А главное вы сохраните взаимопонимание со своими детьми. Правда, пока ребёнок маленький, нас не очень-то и волнует вопрос взаимопонимания. Просто потому, что маленькие дети, как локаторы, настроены на приём. Они принимают наши сигналы (читай: команды, советы), не критикуя и не утруждая себя выяснением: «А зачем мне это надо?» Но чем старше они становятся, тем чаще в их милые головки приходит: «А действительно, зачем мне это надо?» Критичность и лёгкий скептицизм неотъемлемая составляющая роста и осознания себя как личности. А подростку уж просто жизненно важно понять суть наших претензий и требований. Он готов критиковать и сомневаться всегда, даже в ущерб себе, даже рискуя потерять наше расположение и уважение. И родителям надо иметь ангельское терпение, чтоб не поддаться на провокацию и найти, найти, найти контакт. Самый важный шаг к этому избавиться от чувства вины. Напишите на листе бумаги: Винить нельзя помиловать. И поставьте в этом предложении запятую там, где она должна стоять: перед последним словом. Отрывок из книги З. и Н. Некрасовых «Перестаньте детей воспитывать - помогите им расти».Перейти на сайт газеты "Шестая раса"
|
|
Солнцееды: зарождается раса людей, которые ничего не едят |
 По мнению российских ученых, можно считать, что солнцееды - это предтечи новой расы, или даже нового биологического вида.
На Земле по разным подсчетам проживает от нескольких сотен, до 8-10 тысяч индивидов, питающихся энергией Солнца. И по ним можно судить, в какую сторону движется эволюция человека. В насекомое с маленьким телом и огромной головой человек не превращается: он уподобляется... растению. В том смысле, что начинает непосредственно усваивать световую энергию - в точности как представитель флоры. Солнцеедов предтеч нового биологического вида на планете уже тысячи и тысячи.
Рискнул ли кто-то из «видящих будущее» предположить, что шестая раса может оказаться расой солнцеедов? Нет, ясновидящие и футурологи до этого не додумались. К этому пришли обычные ученые. Так, еще в 1880 году русский ученый Сергей Подолинский обратил внимание на то, что труд есть единственный вид работы, который не растрачивает энергию, а напротив, концентрирует ее. Все работающие машины портятся и, поскольку сами заменить изношенных деталей и частей не могут, ломаются. Чтобы стать совершенной в термодинамическом смысле машиной, то есть не растрачивать в процессе работы энергию, а собирать ее, мы должны отказаться от использования запасенной растениями солнечной энергии и напрямую подключиться к Солнцу.
В 1925 году ту же мысль высказал Владимир Вернадский в статье «Автотрофность человечества». Пока человечество в питании зависит от остального растительного и животного мира, оно не может в достаточной степени быть обеспеченным, считал великий ученый. Собственно, это будет уже не человек, а какое-то другое разумное существо...
Сергей Чёрный.
В 2007 году - 21-22 июня - Николай Долгорукий смотрел открытыми глазами на Солнце от восхода до заката 16 часов 28 минут. Он готов продемонстрировать это перед комиссией учёных, врачей, заинтересованных в изучении феномена насыщения солнечной и пространственной энергией.
По мнению российских ученых, можно считать, что солнцееды - это предтечи новой расы, или даже нового биологического вида.
На Земле по разным подсчетам проживает от нескольких сотен, до 8-10 тысяч индивидов, питающихся энергией Солнца. И по ним можно судить, в какую сторону движется эволюция человека. В насекомое с маленьким телом и огромной головой человек не превращается: он уподобляется... растению. В том смысле, что начинает непосредственно усваивать световую энергию - в точности как представитель флоры. Солнцеедов предтеч нового биологического вида на планете уже тысячи и тысячи.
Рискнул ли кто-то из «видящих будущее» предположить, что шестая раса может оказаться расой солнцеедов? Нет, ясновидящие и футурологи до этого не додумались. К этому пришли обычные ученые. Так, еще в 1880 году русский ученый Сергей Подолинский обратил внимание на то, что труд есть единственный вид работы, который не растрачивает энергию, а напротив, концентрирует ее. Все работающие машины портятся и, поскольку сами заменить изношенных деталей и частей не могут, ломаются. Чтобы стать совершенной в термодинамическом смысле машиной, то есть не растрачивать в процессе работы энергию, а собирать ее, мы должны отказаться от использования запасенной растениями солнечной энергии и напрямую подключиться к Солнцу.
В 1925 году ту же мысль высказал Владимир Вернадский в статье «Автотрофность человечества». Пока человечество в питании зависит от остального растительного и животного мира, оно не может в достаточной степени быть обеспеченным, считал великий ученый. Собственно, это будет уже не человек, а какое-то другое разумное существо...
Сергей Чёрный.
В 2007 году - 21-22 июня - Николай Долгорукий смотрел открытыми глазами на Солнце от восхода до заката 16 часов 28 минут. Он готов продемонстрировать это перед комиссией учёных, врачей, заинтересованных в изучении феномена насыщения солнечной и пространственной энергией.
 Подпись к рис «Солнцеед 2»:
Солнцеед Николай Долгорукий.
Подпись к рис «Солнцеед 2»:
Солнцеед Николай Долгорукий.Перейти на сайт газеты "Шестая раса"
|
|
Вся правда о свином гриппе |
Свыше миллиона человек заболели в ноябре 2009 года свиным гриппом на Украине, 189 человек умерли.
В России заболели 3000 человек.
В мире в 2009 году умерли от нового гриппа свыше 6000 человек.
За сутки 11 ноября на Украине заболели 62 тысячи человек, в предыдущие сутки заболела 31 тысяча человек. Таких цифр эпидемии, как на Украине, нет ни в одной стране.
Некоторые СМИ Украины пишут о новом гриппе
как о биологическом оружии, как о начале будущей бактериологической войны.
***
В мае 2009 года, когда впервые мир заговорил о свином гриппе, осталось незамеченным сообщение министра здравоохранения Индонезии Сити Фадилы Супари, которая заявила, что свиной вирус был создан в лаборатории генной инженерии для того, чтобы увеличить прибыли фармацевтических компаний.
Министр заявила, что комбинация свойств вируса вызывает подозрения, что речь идет именно о форме биологического генетического оружия.
По мнению Супари, западные страны, и в первую очередь США, специально разрабатывают и распространяют новые вирусы в других странах, начав с соседней Мексики.
По поводу рекламируемого препарата тамифлю СМИ сообщили, что его выпустили несколько лет назад в больших количествах в преддверии наступления птичьего и свиного гриппа.
В состав тамифлю входит опасное вещество озельтамивир, которое дает очень опасные побочные действия и способствует появлению новых устойчивых штаммов вирусов гриппа.
К препарату тамифлю есть претензии и у Британии. И Япония обвиняет его в убийстве десятков взрослых и детей. Оксфордский университет не рекомендует применять тамифлю детям, подросткам и беременным женщинам.
Представители фармацевтического лобби зарабатывают на тамифлю за две недели по миллиарду долларов. Всемирная организация здравоохранения популяризирует опасные живые вакцины и тамифлю.
Население всего мира стало заложником опасных фармацевтических препаратов и вакцин с живым вирусом свиного гриппа, которые сейчас прививают в пяти регионах России.
***
«Новая газета Украины» задала вопросы нескольким ученым, и они согласились, что любой вирус может служить биологическим оружием, если повысить его вирулентность.
Валерий Полищук, зав. кафедры вирусологии биологического факультета Национального университета, доктор биологических наук:
«Одним из наиболее удобных объектов для биологического оружия как раз является вирус гриппа Но если нет вакцины, пострадают все. Потому что они не имеют над вирусом контроля.
Уже есть доказательства на молекулярно-генетическом уровне, что это странный вирус, своего рода коктейль, состоящий из свиного, человеческого и птичьего вирусов: А/H1N1 «Калифорния».
Когда начали анализировать вирус, оказалось, что его геном характерен для свиного штамма, который раньше человека практически не поражал. Не надо забывать птичьего гриппа, так как по своей патогенности он похож на «испанку», который очень быстро повреждает клетки».
Юрий Сбитнев, член правления Хельсинского медико-социального союза:
«Что касается биологического оружия, о котором пошли слухи, то любая вакцинация, если она проведена неправильно, может расцениваться как биологическое оружие из-за того, что любая вакцинация приводит к ослаблению иммунитета.
В США на проблемы, которые возникают вследствие вакцинации, выплачивают до миллиарда долларов в год.
А у нас парламент принял программу об иммунопрофилактике населения. В ней говорится, что группа риска должна обязательно проходить вакцинирование.
После таких слов министерство здравоохранения нужно назвать министерством по уничтожению населения.
Это биологическая атака против народа Мы не развиваем своей фармацевтической промышленности. В медицине все, что можно, продали и открыли Украину для мирового фармацевтического рынка. Сегодня весь лекарственный мусор запада находится у нас. Украина не вырабатывает никаких препаратов и не проводит профилактических действий. В ее резерве нет самых необходимых средств защиты населения.
Правительство утверждает, что стране требуется 50 миллионов ампул вакцины. Но даже для медиков закрытой является информация, какую именно вакцину собираются завезти на Украину. Притом, что уникальной вакцины против гриппа нет.
А всеобщая вакцинация, которую рекламируют как панацею от гриппа, принесет только вред.
Если ее нужно было проводить, то только за месяц до начала эпидемии.
Уже сейчас в Швеции идет судебный процесс по поводу вакцинации людей от вируса H1N1, от которого умирает больше людей, чем от самого гриппа».
***
В России ситуация точно такая же. Минздравсоцразвития начал прививать людей 9 ноября 2009 года живой вакциной «Инфловир» с живым вирусом гриппа в пяти регионах.
Свыше миллиона человек заболели в ноябре 2009 года свиным гриппом на Украине, 189 человек умерли.
В России заболели 3000 человек.
В мире в 2009 году умерли от нового гриппа свыше 6000 человек.
За сутки 11 ноября на Украине заболели 62 тысячи человек, в предыдущие сутки заболела 31 тысяча человек. Таких цифр эпидемии, как на Украине, нет ни в одной стране.
Некоторые СМИ Украины пишут о новом гриппе
как о биологическом оружии, как о начале будущей бактериологической войны.
***
В мае 2009 года, когда впервые мир заговорил о свином гриппе, осталось незамеченным сообщение министра здравоохранения Индонезии Сити Фадилы Супари, которая заявила, что свиной вирус был создан в лаборатории генной инженерии для того, чтобы увеличить прибыли фармацевтических компаний.
Министр заявила, что комбинация свойств вируса вызывает подозрения, что речь идет именно о форме биологического генетического оружия.
По мнению Супари, западные страны, и в первую очередь США, специально разрабатывают и распространяют новые вирусы в других странах, начав с соседней Мексики.
По поводу рекламируемого препарата тамифлю СМИ сообщили, что его выпустили несколько лет назад в больших количествах в преддверии наступления птичьего и свиного гриппа.
В состав тамифлю входит опасное вещество озельтамивир, которое дает очень опасные побочные действия и способствует появлению новых устойчивых штаммов вирусов гриппа.
К препарату тамифлю есть претензии и у Британии. И Япония обвиняет его в убийстве десятков взрослых и детей. Оксфордский университет не рекомендует применять тамифлю детям, подросткам и беременным женщинам.
Представители фармацевтического лобби зарабатывают на тамифлю за две недели по миллиарду долларов. Всемирная организация здравоохранения популяризирует опасные живые вакцины и тамифлю.
Население всего мира стало заложником опасных фармацевтических препаратов и вакцин с живым вирусом свиного гриппа, которые сейчас прививают в пяти регионах России.
***
«Новая газета Украины» задала вопросы нескольким ученым, и они согласились, что любой вирус может служить биологическим оружием, если повысить его вирулентность.
Валерий Полищук, зав. кафедры вирусологии биологического факультета Национального университета, доктор биологических наук:
«Одним из наиболее удобных объектов для биологического оружия как раз является вирус гриппа Но если нет вакцины, пострадают все. Потому что они не имеют над вирусом контроля.
Уже есть доказательства на молекулярно-генетическом уровне, что это странный вирус, своего рода коктейль, состоящий из свиного, человеческого и птичьего вирусов: А/H1N1 «Калифорния».
Когда начали анализировать вирус, оказалось, что его геном характерен для свиного штамма, который раньше человека практически не поражал. Не надо забывать птичьего гриппа, так как по своей патогенности он похож на «испанку», который очень быстро повреждает клетки».
Юрий Сбитнев, член правления Хельсинского медико-социального союза:
«Что касается биологического оружия, о котором пошли слухи, то любая вакцинация, если она проведена неправильно, может расцениваться как биологическое оружие из-за того, что любая вакцинация приводит к ослаблению иммунитета.
В США на проблемы, которые возникают вследствие вакцинации, выплачивают до миллиарда долларов в год.
А у нас парламент принял программу об иммунопрофилактике населения. В ней говорится, что группа риска должна обязательно проходить вакцинирование.
После таких слов министерство здравоохранения нужно назвать министерством по уничтожению населения.
Это биологическая атака против народа Мы не развиваем своей фармацевтической промышленности. В медицине все, что можно, продали и открыли Украину для мирового фармацевтического рынка. Сегодня весь лекарственный мусор запада находится у нас. Украина не вырабатывает никаких препаратов и не проводит профилактических действий. В ее резерве нет самых необходимых средств защиты населения.
Правительство утверждает, что стране требуется 50 миллионов ампул вакцины. Но даже для медиков закрытой является информация, какую именно вакцину собираются завезти на Украину. Притом, что уникальной вакцины против гриппа нет.
А всеобщая вакцинация, которую рекламируют как панацею от гриппа, принесет только вред.
Если ее нужно было проводить, то только за месяц до начала эпидемии.
Уже сейчас в Швеции идет судебный процесс по поводу вакцинации людей от вируса H1N1, от которого умирает больше людей, чем от самого гриппа».
***
В России ситуация точно такая же. Минздравсоцразвития начал прививать людей 9 ноября 2009 года живой вакциной «Инфловир» с живым вирусом гриппа в пяти регионах.
 От этой вакцины в Швеции умерло больше людей, чем от самого гриппа.
Забайкальский край отказался от живой вакцины, (я донесла информацию об ее опасности),
Забайкальский и Читинский Минздрав потребовал от правительства России прислать инактивированную вакцину против свиного гриппа.
26 сентября 2009 года в мировой сети появилось видеообращение испанской монахини Тересы Форкадес, в котором она, доктор медицины, бывший врач, приводит научные факты и аномальные примеры, говорящие об опасности прививок от гриппа A/H1N1.
Тереса Форкадес сообщила: « В феврале 2009 года американский фармацевтический гигант Вахter и его австрийская штаб-квартира разослали в 16 лабораторий четырех европейских стран 62 килограмма субстанции для производства вакцины от сезонного гриппа.
Совершенно случайным образом техник одной из лабораторий Чехии обнаружил, что субстанция заражена двумя живыми вирусами гриппа.
Один вирус сезонный, обычный, имеющий в своих характеристиках низкую степень смертности, а другой вирус с низкой распространяемостью, но высокой смертностью (около 60 процентов).»
Вероятно, население Украины и некоторых регионов России стало заложниками тайных экспериментов бактериологической войны. Этот вопрос в России не освещается, ни один телеканал не рассказал об эпидемии свиного гриппа на Украине. Наоборот, российские телеканалы показывают митинги молодых придурков от партии Януковича, кричащих, что на Украине нет никакой эпидемии.
***
Ни один телеканал России не прореагировал на сообщение газеты «Аргументы недели» о нелегальной фарминдустрии, создавшей вирус свиного гриппа в нью-йоркском картеле, который входит в траст « Рокфеллер Фаундейшн» мультимиллиардера Дэвида Рокфеллера.
Американские журналисты, открывшие этот факт, подали документы в ФБР. Но там полное молчание. Заговор траста Рокфеллера, в котором участвовали могущественные мультимиллиардеры-медиамагнаты Мэрдок, Глоуссер, Спреейр, спровоцировавшие глобальный геноцид с помощью генетического оружия, создавая опасные вирусы и вирус A/H1N1, не обсуждается мировыми СМИ. Дискуссии на публикацию «Аргументов недели» нет и в России.
Недавно я увидела по телеканалу «Совершенно секретно» программу о страшной опасности генетического оружия. Искусственное создание штаммов бактерий и вирусов, измененных с помощью технологии генной инженерии - это генетическое оружие страшнее ядерного.
***
В недавнем отчете членов Британской медицинской ассоциации сказано: «Есть предположение, что в ближайшие десятилетия может быть создано генетическое оружие массового поражения. Развитие генетики способно стать в ближайшие годы причиной этнических чисток».
***
От атипичной пневмонии в 2003 году никто не создал вакцину.
Эта инфекция охватила тогда 24 страны, продолжалась полгода, ею заболели восемь тысяч человек. Но больше всех пострадал Китай, где от нее умерли 700 человек.
Что это было? Предтеча свиного гриппа? А может быть, это и был сам свиной грипп?
Ни в Китае, ни во Вьетнаме раньше ничего подобного не было. Значит, речь может идти об этническом бактериологическом оружии, созданном с помощью генной инженерии, которое действует выборочно на определенные расы людей.
Атипичная пневмония 2003 года погубила больше всего людей желтой расы.
Китаю был нанесен экономический ущерб 9 миллиардов долларов. Так США и их сателлиты в Европе намеренно «пощупали» Китай на предмет наличия там бактериологического оружия. В Китае умирают в тюрьмах тысячи людей, недовольных властью и зарплатой в 10 долларов. Но это не значит, что на них нужно испытывать генетическое оружие.
Александр Баранов, сотрудник института биологии РАН, сказал в фильме «Совершенно Секретно»
«Генная инженерия страшная вещь, страшнее атомного оружия. Это такое будет! Причем, остановить это мы не сможем».
Японцы имели самую мощную программу по разработке биологического оружия, на втором месте были США. В 1974 году был подписан договор о запрете бактериологического оружия.
Однако исследования по созданию избирательного действия вирусов не прекращаются до сих пор. Искусственно созданные штаммы вирусов и бактерий с помощью генной инженерии могут вносить в организм человека гены-убийцы выборочно, в зависимости от пола, возраста и антропологических признаков.
Сергей Колесников, ученый РАН: « Цель военных создать вирус, который более активен против одной расы и менее активен в отношении другой. В 1975 году, во время освобождения Анголы от нападения ЮАР, повстанцы начали пухнуть от странной болезни, когда жидкость не выводилась из организма, и через месяц они умирали. Болезнь не действовала на советских специалистов и белокожих иностранцев».
***
Мировое сообщество, ООН, Евросоюз должны не только поставить под контроль все секретные государственные и частные лаборатории по разработке генетического оружия, но и запретить это оружие.
Рокфеллер и Мэрдок должны предстать перед Гаагским трибуналом за создание вируса A/H1N1 и других разработок генетического оружия.
Наталья Глазкова.
От этой вакцины в Швеции умерло больше людей, чем от самого гриппа.
Забайкальский край отказался от живой вакцины, (я донесла информацию об ее опасности),
Забайкальский и Читинский Минздрав потребовал от правительства России прислать инактивированную вакцину против свиного гриппа.
26 сентября 2009 года в мировой сети появилось видеообращение испанской монахини Тересы Форкадес, в котором она, доктор медицины, бывший врач, приводит научные факты и аномальные примеры, говорящие об опасности прививок от гриппа A/H1N1.
Тереса Форкадес сообщила: « В феврале 2009 года американский фармацевтический гигант Вахter и его австрийская штаб-квартира разослали в 16 лабораторий четырех европейских стран 62 килограмма субстанции для производства вакцины от сезонного гриппа.
Совершенно случайным образом техник одной из лабораторий Чехии обнаружил, что субстанция заражена двумя живыми вирусами гриппа.
Один вирус сезонный, обычный, имеющий в своих характеристиках низкую степень смертности, а другой вирус с низкой распространяемостью, но высокой смертностью (около 60 процентов).»
Вероятно, население Украины и некоторых регионов России стало заложниками тайных экспериментов бактериологической войны. Этот вопрос в России не освещается, ни один телеканал не рассказал об эпидемии свиного гриппа на Украине. Наоборот, российские телеканалы показывают митинги молодых придурков от партии Януковича, кричащих, что на Украине нет никакой эпидемии.
***
Ни один телеканал России не прореагировал на сообщение газеты «Аргументы недели» о нелегальной фарминдустрии, создавшей вирус свиного гриппа в нью-йоркском картеле, который входит в траст « Рокфеллер Фаундейшн» мультимиллиардера Дэвида Рокфеллера.
Американские журналисты, открывшие этот факт, подали документы в ФБР. Но там полное молчание. Заговор траста Рокфеллера, в котором участвовали могущественные мультимиллиардеры-медиамагнаты Мэрдок, Глоуссер, Спреейр, спровоцировавшие глобальный геноцид с помощью генетического оружия, создавая опасные вирусы и вирус A/H1N1, не обсуждается мировыми СМИ. Дискуссии на публикацию «Аргументов недели» нет и в России.
Недавно я увидела по телеканалу «Совершенно секретно» программу о страшной опасности генетического оружия. Искусственное создание штаммов бактерий и вирусов, измененных с помощью технологии генной инженерии - это генетическое оружие страшнее ядерного.
***
В недавнем отчете членов Британской медицинской ассоциации сказано: «Есть предположение, что в ближайшие десятилетия может быть создано генетическое оружие массового поражения. Развитие генетики способно стать в ближайшие годы причиной этнических чисток».
***
От атипичной пневмонии в 2003 году никто не создал вакцину.
Эта инфекция охватила тогда 24 страны, продолжалась полгода, ею заболели восемь тысяч человек. Но больше всех пострадал Китай, где от нее умерли 700 человек.
Что это было? Предтеча свиного гриппа? А может быть, это и был сам свиной грипп?
Ни в Китае, ни во Вьетнаме раньше ничего подобного не было. Значит, речь может идти об этническом бактериологическом оружии, созданном с помощью генной инженерии, которое действует выборочно на определенные расы людей.
Атипичная пневмония 2003 года погубила больше всего людей желтой расы.
Китаю был нанесен экономический ущерб 9 миллиардов долларов. Так США и их сателлиты в Европе намеренно «пощупали» Китай на предмет наличия там бактериологического оружия. В Китае умирают в тюрьмах тысячи людей, недовольных властью и зарплатой в 10 долларов. Но это не значит, что на них нужно испытывать генетическое оружие.
Александр Баранов, сотрудник института биологии РАН, сказал в фильме «Совершенно Секретно»
«Генная инженерия страшная вещь, страшнее атомного оружия. Это такое будет! Причем, остановить это мы не сможем».
Японцы имели самую мощную программу по разработке биологического оружия, на втором месте были США. В 1974 году был подписан договор о запрете бактериологического оружия.
Однако исследования по созданию избирательного действия вирусов не прекращаются до сих пор. Искусственно созданные штаммы вирусов и бактерий с помощью генной инженерии могут вносить в организм человека гены-убийцы выборочно, в зависимости от пола, возраста и антропологических признаков.
Сергей Колесников, ученый РАН: « Цель военных создать вирус, который более активен против одной расы и менее активен в отношении другой. В 1975 году, во время освобождения Анголы от нападения ЮАР, повстанцы начали пухнуть от странной болезни, когда жидкость не выводилась из организма, и через месяц они умирали. Болезнь не действовала на советских специалистов и белокожих иностранцев».
***
Мировое сообщество, ООН, Евросоюз должны не только поставить под контроль все секретные государственные и частные лаборатории по разработке генетического оружия, но и запретить это оружие.
Рокфеллер и Мэрдок должны предстать перед Гаагским трибуналом за создание вируса A/H1N1 и других разработок генетического оружия.
Наталья Глазкова.Перейти на сайт газеты "Шестая раса"
|
|
Три рождения человека |
Существует три рождения человека. Первое знакомо всем это физическое рождение. Кто-то родился легко и без последствий, кому-то пришлось потрудиться и даже пострадать, чтобы появиться на белом свете, а кто-то вышел с проблемами Но раз вы читаете этот журнал, значит, первое рождение состоялось.
Второе рождение психическое. Здесь уже не все так просто, и, скорее всего, многие из читателей еще не прошли этот этап жизни. Психическое рождение сложный психологический процесс, это становление зрелого человека, выход его в самостоятельную жизнь. Поэтому психическое рождение вопрос для кого-то еще открытый. Многие скажут: «Мы давно уже самостоятельные, у нас уже дети, а то и внуки!» Но не спешите. Наличие солидного вида, большого счета в банке, детей и даже внуков еще не гарантирует состояния зрелого человека! Если физическое рождение явно заметно, к нему готовятся, и это становится событием для многих людей, то психические роды проходят незаметно, поэтому мало кто даже задумывается об этом очень важном этапе жизни каждого человека.
Психическое рождение процесс выхода человека из-под психологической опеки родителей и рода и становление его как самостоятельной, самодостаточной, зрелой личности.
В последнее время часто можно услышать от женщин такие слова: «Разве можно сейчас встретить настоящего мужчину? Они перевелись!» И вы знаете, как ни горько, но следует признать, что, действительно, истинно мужские качества силу, доброту, волю, великодушие, творчество и реализованность увидеть в одном мужчине довольно трудно. С чем это связано? О причинах и путях решения этой задачи поговорим позже, а пока надо обозначить саму проблему, так как многие раньше и не задумывались об этом.
Важный процесс развития человека пущен на самотек. Систематически, целенаправленно психическим рождением не занимаются ни в семье, ни в обществе.
В старину существовали традиции и ритуалы посвящений, инициаций (у некоторых народов они сохранились и по сей день). У нас из этого наследия ничего не сохранилось. В результате психически не рожденные люди берутся за дела (от создания семьи до управления государством), для них невыполнимые. От этого страдают и они сами, и окружающие люди.
В психологии и сексологии уже существует целое направление, которое изучает интимофобию состояние несозревшего человека, нежелающего создавать семью. Такие мужчины могут иметь частые отношения с женщинами, в том числе сексуальные. Они могут быть прекрасными, чуткими поклонниками, уметь завладеть женским сердцем, утешить, но создание семьи для них очень сложная задача. И если интимофобы не спиваются, то после пятидесяти могут попытаться создать семью. Иногда под влиянием женщины, матери или окружающих они женятся раньше, но семья для них становится не творческим полигоном, а необходимостью или даже обузой, которую они терпят или не терпят, меняя жен.
Интимофобия, или психическое нерождение, стала уже проблемой глобальной. Более 30 % мужчин страдают этим психическим заболеванием, еще более усугубляя ситуацию с одинокими женщинами, желающими выйти замуж и создать полноценную семью.
30 % это те, в которых явно видны признаки глубокой болезни, а вообще психически не до конца рожденных мужчин около 60 %! И правы женщины, говорящие, что сейчас нет «настоящих мужчин», вот только они не понимают, что главной причиной такой ситуации являются они сами.
Через призму психического рождения нужно рассматривать не только семейные проблемы, но и общественные, государственные, бизнес.
Нередко эти мужчины высокообразованны, так как любящие матери приложили к этому много усилий. Матери загружают детей знаниями, разными кружками, секциями, стараются воспитать из мальчика настоящего «мужчину», а происходит обратное. Интимофобы могут занимать хорошие посты, так как имеют возможность много времени уделять работе, карьере. Такого психически не рожденного человека можно встретить и в Думе, и в правительстве, много их в творческой среде, в науке. Профессор МГУ А. М. Полеев утверждает, что 80 % лауреатов Нобелевской премии интимофобы. То есть это негармоничные люди, которые почти всю жизнь посвящают какому-то одному любимому делу. Для них творчество, дело, карьера, политика, деньги любимее женщины, ценнее семьи.
Отсутствие желания создать семью такой человек объясняет стандартным набором причин: «Я не люблю детей», «Женщины коварны», «Она очень умная» (или наоборот глупая), «У нас разные интересы», «У нас слишком много общего скучно», «Я ищу свою половинку», «В мире так много интересного и без женщин» и т. д. Психическая травма, нанесенная избыточным материнским чувством, часто отражается и на сексуальных способностях, и это тоже может быть причиной избегания мужчиной длительных или всяких отношений с женщинами.
Не рожденный психически человек в любом возрасте остается неадекватным. Ему трудно принять верное решение, так как он находится в психической утробе матери, в так называемой «психической плаценте», и воспринимает окружающий мир через ее чувства и менталитет. (Даже если мать далеко или уже ушла из жизни, влияние родительской плаценты продолжает сказываться.) А это зачастую входит в противоречие с собственными представлениями человека о мире, в результате происходят сложные процессы, приводящие к психическим расстройствам, употреблению алкоголя, наркотиков, что делает сложным взаимодействие человека с другими людьми.
Естественно, в таком состоянии трудно реализоваться в жизни, трудно быть мужчиной. Интимофобы боятся глубоких, доверительных отношений с женщинами, боятся ответственности. Крайнее состояние интимофобии уже относится к сексопатологии. Так называемые мизогинисты избегают женщин. Они тоже составляют значительный процент мужского населения, а в целом это большое количество (около 100 миллионов мужчин на Земле!). Они выбирают удаленные от общества профессии, уходят в дальние путешествия, с головой погружаются в работу Изредка могут иметь половые отношения, но кратковременные, без чувств и желательно с незнакомой женщиной, чтобы удовлетворить чисто физиологическую потребность и не касаться душевной сферы.
Как видим, вопрос психической зрелости совсем не прост! Чтобы успешно вести бизнес, решать жизненные вопросы, нужно самому психически родиться и уметь видеть в окружающих, кто есть кто. Иначе можно получить проблемы «на ровном месте», с той стороны, откуда и не ждешь: от сотрудника, на которого положился, от партнера, с которым начал дело, от друга, с которым знаком с детства
Я предлагаю простой тест, позволяющий легко, но довольно точно определить зрелость человека.
Если человек думает только о себе и все делает в основном для себя это взрослый ребенок ясельного возраста.
Если человек думает о себе и о своей семье и все делает для себя и для своей семьи это взрослый ребенок детсадовского возраста.
Если человек думает о себе, о своей семье и о своем роде и все делает для себя, для своей семьи и для своего рода это взрослый подросток.
Если человек думает о себе, о своей семье, о своем роде и о своем народе и все делает для себя, для своей семьи, для своего рода и для своего народа это взрослый юноша.
Если человек думает о себе, о своей семье, о своем роде, о своем народе и о Земле в целом и все делает для себя, для своей семьи, для своего рода, для своего народа и для Земли это зрелый взрослый.
Вот теперь вы можете с интересом посмотреть на окружающих в какие игры они играют? И не важно, какого размера игрушка: новейший телефон, дорогие часы, навороченный автомобиль, маленький версаль за городом, крупный счет в банке, депутатский значок... Игрушка остается игрушкой, и она четко показывает масштаб мышления человека, степень его зрелости. Не забудьте также честно посмотреть в зеркало А в какие игры играете вы? И если заметите у себя мелкий масштаб, не паникуйте, поставьте перед собой задачу достижения психической зрелости. Помните, что ресурсы даются человеку в соответствии с масштабом его мышления, и если он попытается взять ресурсы, не соответствующие его масштабу, например, начать большой проект, возникнут трудности и проблемы. На основе вышесказанного составим портрет взрослого, но психически не рожденного человека:
большая зависимость от родителей и родственников или (и) сложные отношения с ними;
проявление детских, подростковых, юношеских качеств (обида, зависть, гневливость, агрессивность, нетерпимость, максимализм, осуждение окружающих, ревность);
нарушенная естественная система ценностей (о ней мы говорили в предыдущем номере);
стремление к самоутверждению через власть, карьеру, богатство, спорт, секс, моду;
отсутствие ярко выраженной женственности или мужественности;
сложности в построении семьи, в семейных отношениях;
ограниченная сфера жизни (работа семья, работа хобби);
фанатизм религиозный, духовный, политический, научный, спортивный (фанатизм в работе это тоже признак психической незрелости);
наличие хронических и тяжелых болезней;
много начатых и не доведенных до конца дел;
мелкий масштаб мышления.
Как видим, отсутствие психической зрелости создает проблемы как самому человеку, так и окружающим людям, обществу. Сплошь и рядом мы видим, что творят психически незрелые чиновники, политики, руководители всех рангов
Не рожденный психически человек в любом возрасте остается неадекватным. Ему трудно принять верное решение, так как он находится в психической утробе матери и воспринимает окружающий мир через ее чувства и менталитет.
Таким образом, психическое рождение это важный шаг к личной зрелости, к полноценной и счастливой жизни. Главные причины психической незрелости находятся в роду, в родителях. Нарушенная система ценностей, избыточное родительское (и в первую очередь, материнское) чувство в адрес детей вот что лежит в основе этой глобальной социальной проблемы. Таким образом, во взрослую жизнь из сегодняшних семей зачастую выходят незрелые, не готовые к взрослой жизни люди.
Осознание самой задачи это уже половина ее решения! Имея стремление, каждый человек может сам себе помочь психически родиться.
Для того чтобы психические роды состоялись, человеку нужно сделать следующее.
Осознать и принять свое сегодняшнее состояние психической незрелости. Бывает непросто это сделать гордыня мешает увидеть в себе элементы незрелости, но это первый и обязательный шаг.
Привести в соответствие систему ценностей и выстроить основные фрагменты мировоззрения. Для этого нужна определенная работа над собой, но лень нередко встает на пути Сейчас достаточно различной литературы и образовательных программ на эту тему.
Выстроить отношения с отцом. Понять роль отца в жизни и укрепить его мужские качества. Это очень важный ключ к решению задачи.
Выстроить отношения с матерью. Основной вектор помочь ей стать женщиной. (Если родителей нет рядом или они ушли из жизни, нужна глубокая работа со своим сознанием.)
Выстроить в себе баланс материнских и отцовских энергий. Нужно в мыслях и чувствах иметь равное отношение и к отцу, и к матери.
Построить отношения с родственниками. Нужно сделать три шага к роду.
Взять ответственность за свою жизнь на себя. Зрелый человек не перекладывает ответственность на других.
Развивать масштабность личности. Занять активную жизненную позицию.
Идти по жизни последовательно и поступательно. Не прожектерствовать и не перескакивать через ступени. Начинать с малого и шагать без остановки. В этом случае происходит наиболее эффективное развитие, и в «тылу» не остаются нерешенные задачи.
С каждым человеком в своем окружении выстроить добрые, уважительные и дружеские отношения.
Раскрыть и проявить лучшие мужские (женщинам, соответственно, женские) качества.
Осознать важность сексуальных отношений и научиться мудро использовать сексуальные энергии.
Понять величайшую роль семьи. Стать профессионалом в семейных отношениях.
Найти свое дело и принести пользу обществу.
Данный вопрос мы рассмотрели на примере мужчин. Но психически не рожденных женщин также можно встретить достаточно много, их в мире, в среднем, около 40 %. Поэтому то, о чем говорится в этой статье, относится и к женщинам. Но так как психическое рождение женщины часто происходит во время ее беременности и родов, таких не рожденных женщин все-таки меньше, чем мужчин.
О психически не рожденных женщинах стоит сказать особо. Девушки зачастую слишком рано выходят замуж, «перескакивают» через ступень психического рождения женщины и сразу становятся матерями. Быстрая (сразу после свадьбы, а то и до нее) беременность, отсутствие рядом психически рожденного мужчины, отсутствие положительных примеров в семье и обществе все это приводит к тому, что молодая женщина становится матерью не только ребенка, но и мужа. Женщины, проявляющие избыточное материнское чувство, являются психически не рожденными. Часто, спустя много лет, когда дети подрастают, в женщине происходит психическое рождение, и на этой почве происходит конфликт с психически не рожденным мужем. Муж-ребенок перестает удовлетворять созревшую женщину. Нередко и мужчина созревает к определенному возрасту. Это происходит через активную общественную жизнь, взаимодействие со зрелыми женщинами. И если дома жена по-прежнему играет роль «мамочки», она становится ему неинтересной.
Конфликт психически рожденных с не рожденными это сильный, всеразрушающий конфликт. Его можно убрать только через психическое рождение второй половины или через смену партнеров. А многие не делают ни того, ни другого, постоянно живут в состоянии конфликта, разрушая здоровье, делая из семьи брак и закладывая детям и последующим поколениям огромные проблемы.
Юристы говорят: «Незнание законов не освобождает от ответственности». Это относится и к законам жизни. Сегодня жизненно необходимо быть осознанным время сейчас особенное.
Через призму психического рождения нужно рассматривать не только семейные проблемы, но и общественные, государственные, бизнес. Психически не рожденных людей особенно много в структурах власти и политики, в армии, бизнесе, то есть там, где решаются судьбы многих людей. Их там наибольшее количество, свыше 80 %. Поэтому так важно дать людям необходимые знания и создать в обществе условия для решения этой задачи.
Отсутствие психической зрелости создает проблемы и при преодолении следующей ступени в развитии человека в духовном рождении. Часто можно видеть, как люди, психически не рожденные, входят в духовные сферы. И там они остаются неполноценными, несмотря на духовные звания и посвящения. Вот мы подошли к третьему рождению духовному.
Часто духовность путают с религиозностью, это далеко не всегда тождественно. Духовный человек человек, раскрывший свое сознание за пределы Земли, осознающий единство и взаимосвязь Мира, проявляющий в жизни самые высокие человеческие качества, творящий добро для себя и людей, живущий счастливо.
Многие, увлекаясь материальными вопросами, деятельностью и творчеством в сфере бизнеса, политики, искусства, науки, игнорируют этот этап своего развития или подменяют духовность исполнением религиозных ритуалов и пожертвованиями в церковь. Между тем, духовное рождение необходимый и обязательный этап! Если он не состоялся, то жизнь человека может оказаться на волоске. В основном по этой причине уходят из жизни люди в возрасте около сорока лет. И уходят талантливые! И это понятно кому много дается, с того много и спрашивается.
Несколько слов о сроках психического и духовного рождения. Оптимально психически родиться до 27 лет. До этого времени человеку еще даются «кредиты», идет помощь от Мира. После 27 лет Мир уже начинает спрашивать, как использовались данные «кредиты», и требовать их возврата приходит время отдавать Миру. 33 года оптимальный возраст для духовного рождения. Каждый последующий год затягивания процесса рождения приводит к нарастанию проблем, и многие могут отследить в жизни сказанное.
Юристы говорят: «Незнание законов не освобождает от ответственности». Это относится и к законам жизни. Сегодня жизненно необходимо быть осознанным время сейчас особенное. Обратите внимание, как оно ускорилось! И еще посмотрите как быстро растут кладбища. Их заполняют те, кто не успевает за временем, кто не желает быть осознанным и развиваться
Анатолий НЕКРАСОВ.
Подпись к рис. «Три рождения человека 2»:
Не рожденный психически человек в любом возрасте остается неадекватным. Ему трудно принять верное решение, так как он находится в психической утробе матери, в так называемой «психической плаценте», и воспринимает окружающий мир через ее чувства и менталитет.
Перейти на сайт газеты "Шестая раса"
Перейти на сайт газеты "Шестая раса"
|
|






